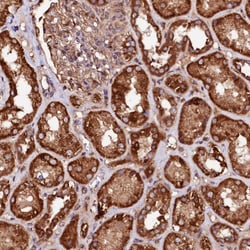
Invitrogen ST3GAL1 Polyclonal Antibody 100 &mu;L | Buy Online | Invitrogen&trade; | Fisher Scientific

missing translation for 'onlineSavingsMsg'
Learn More
Learn More
Description
Immunogen sequence: MVLELSENLK RLIKHRPCTC THCIGQRKLS AWFDERFNQT MQPLLTAQNA LLEDDTYRWW LRLQREKKPN NLNDTIKELF RVVPGNVDPM LEKRSVGCRR CAVVGNSGNL RESSYGPEID SHDFVLRMNK APTAGFEA Highest antigen sequence identity to the following orthologs: Mouse - 81%, Rat - 80%.
ST3GAL1 is a type II membrane protein that catalyzes the transfer of sialic acid from CMP-sialic acid to galactose-containing substrates. It is normally found in the Golgi but can be proteolytically processed to a soluble form. Correct glycosylation of ST3GAL1 protein may be critical to its sialyltransferase activity. This protein, which is a member of glycosyltransferase family 29, can use the same acceptor substrates as does sialyltransferase 4B.The protein encoded by this gene is a type II membrane protein that catalyzes the transfer of sialic acid from CMP-sialic acid to galactose-containing substrates. The encoded protein is normally found in the Golgi but can be proteolytically processed to a soluble form. Correct glycosylation of the encoded protein may be critical to its sialyltransferase activity. This protein, which is a member of glycosyltransferase family 29, can use the same acceptor substrates as does sialyltransferase 4B. Two transcript variants encoding the same protein have been found for this gene. Other transcript variants may exist, but have not been fully characterized yet.

Spécification
Spécification
| Antigène | ST3GAL1 |
| Applications | Immunohistochemistry (Paraffin), Western Blot |
| Classification | Polyclonal |
| Concentration | 0.10 mg/mL |
| Conjugué | Unconjugated |
| Formule | PBS with 40% glycerol and 0.02% sodium azide; pH 7.2 |
| Expression | ST3GAL1 |
| Numéro d’ordre du gène | Q11201 |
| Alias de gène | 5330418N22Rik; AI467004; Alpha 2,3-ST 1; alpha-2,3-sialyltransferase ST3Gal I-r1; alpha-2-3-sialyltransferase; beta-galactoside alpha-2,3-sialyltransferase 1; CMP-N-acetylneuraminate: [beta-galactosidase alpha-2,3] sialytransferase; CMP-N-acetylneuraminate-beta-galactosamide-alpha-2,3-sialyltransferase 1; Gal beta1,3 GalNAc alpha2,3 sialyltransferase; Gal-beta-1,3-GalNAc-alpha-2,3-sialyltransferase; Gal-NAc6S; MGC9183; putative alpha-2,3-sialyltransferase; Sialyltransferase 4A; sialyltransferase 4A (beta-galactosidase alpha-2,3-sialytransferase); sialyltransferase 4A (beta-galactoside alpha-2,3-sialyltransferase); sialyltransferase 4A (beta-galactoside alpha-2,3-sialytransferase); sialyltransferase ST3Gal-I; Siat4; SIAT4A; SIAT4-A; siat4-r1; SIATFL; ST3 beta-galactoside alpha-2,3-sialyltransferase 1; ST3Gal I; st3Gal I.1; ST3GAL1; St3gal-1; st3gal1A; st3gal1-r1; ST3GAL2; ST3GalA; ST3GalA.1; ST3GalI; ST3GAL-I sialyltransferase; ST3GalIA; ST3GalIA,1; ST3O |
| Symboles de gène(s) | ST3GAL1 |
| Afficher plus |
Nom du produit
En cliquant sur Soumettre, vous reconnaissez que vous pouvez être contacté par Fisher Scientific au sujet des informations que vous avez fournies dans ce formulaire. Nous ne partagerons pas vos informations à d'autres fins. Toutes les informations de contact fournies seront également conservées conformément à notre politique de confidentialité. Politique de confidentialité.
Vous avez repéré une opportunité d'amélioration ?